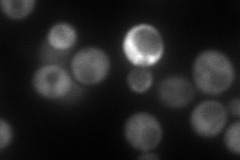
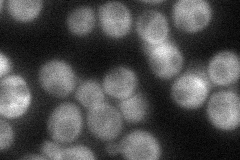
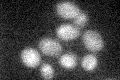

View description
Nitrogen catabolite repression transcriptional regulator that acts by inhibition of GLN3 transcription in good nitrogen source; has glutathione peroxidase activity and can mutate to acquire GST activity; altered form creates [URE3] prion
Localization:
Intensity:
Fold change:
Significance:
-
C’ GFP library in SD

below threshold16.89 -
N' NOP1pr-GFP in SD

cytosol89.1933 -
N' TEF2pr-mCherry in SD
cytosol145.952 -
N' NATIVEpr-GFP in SD
cytosol58.7187 -
N' TEF2pr-VC and Cyto-VN in SD

cytosol58.7921 -
C’ GFP library in SD+DTT

cytosol14.640.86No -
C’ GFP library in SD+H2O2

cytosol19.481.15No -
C’ GFP library in Starvation Media
cytosol28.541.68No -
C’ GFP library on the background of Pup2-DaMP

below threshold -
C’ GFP library on the background of CCT mutant

below threshold16.62530.983967No
